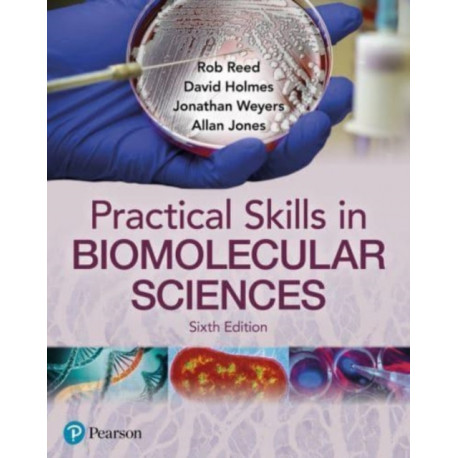
Practical Skills in Biomolecular Science

Kurv
Vare
varer
(tom)
Ingen varer
Fastlægges senere
Forsendelse
0,- kr
I alt
Practical Skills in Biomolecular Science
(Bog, Paperback / softback, Engelsk)
Forlag:
Pearson Education Limited
- Type: Bog
- Format: Paperback / softback
-
Sprog:
Engelsk

- ISBN-13: 9781292397085
- Se flere detaljer ▼
Læsernes anmeldelser (0)
Alle detaljer
| Forlag | Pearson Education Limited |
| Forfattere | Rob Reed, David Holmes, Jonathan Weyers, Allan Jones |
| Type | Bog |
| Format | Paperback / softback |
| Sprog | Engelsk |
| Udgave | 6 ed |
| Udgivelsesdato | 22-12-2021 |
| Første udgivelsesår | 2021 |
| Originalsprog | United Kingdom |
| Sideantal | 656 |
| Indbinding | Paperback / softback |
| Forlag | Pearson Education Limited |
| Sideoplysninger | 656 pages |
| Mål | 286 x 290 x 36 |
| ISBN-13 / EAN-13 | 9781292397085 |

